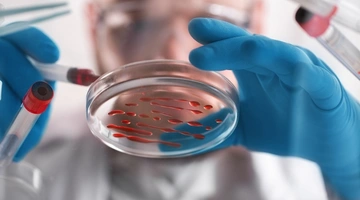
karkinos-aimatos

Οι γυναίκες με σύνδρομο πολυκυστικών ωοθηκών μπορεί να έχουν περισσότερες πιθανότητες να αντιμετωπίσουν προβλήματα μνήμης στη μέση ηλικία, σύμφωνα με έρευνα που δημοσιεύθηκε στο ηλεκτρονικό τεύχος του ιατρικού περιοδικού της Αμερικανικής Ακαδημίας Νευρολογίας «Neurology».
Το σύνδρομο πολυκυστικών ωοθηκών είναι μια ορμονική διαταραχή που ορίζεται από ακανόνιστη έμμηνο ρύση και αυξημένα επίπεδα ανδρογόνου. Άλλα συμπτώματα μπορεί να περιλαμβάνουν υπερβολική τριχοφυΐα, ακμή, υπογονιμότητα και κακή μεταβολική υγεία. Ωστόσο, δεν είναι γνωστή η επίδρασή του στις λειτουργίες του εγκεφάλου.
Στην παρούσα μελέτη συμμετείχαν 907 γυναίκες, ηλικίας 18-30 ετών κατά την έναρξή της. Παρακολουθήθηκαν για 30 χρόνια και έπειτα συμπλήρωσαν τεστ για τη μέτρηση της μνήμης, των λεκτικών ικανοτήτων, της ταχύτητας επεξεργασίας και της προσοχής. Κατά την περίοδο του τεστ, 66 συμμετέχουσες είχαν σύνδρομο πολυκυστικών ωοθηκών.
Όπως διαπιστώθηκε, οι συμμετέχουσες με σύνδρομο πολυκυστικών ωοθηκών είχαν χαμηλότερες βαθμολογίες στα τεστ που έγιναν για τη μνήμη, την προσοχή και τις λεκτικές ικανότητες, σε σύγκριση με τις συμμετέχουσες χωρίς την πάθηση.
Ep;ishw, s;σύμφωνα με το ΑΠΕ-ΜΠΕ, κατά τη διάρκεια της έρευνας, μια μικρότερη ομάδα 291 γυναικών έκανε απεικονιστικούς ελέγχους του εγκεφάλου. Οι ερευνητές εντόπισαν ότι οι γυναίκες με σύνδρομο πολυκυστικών ωοθηκών είχαν χαμηλότερη ακεραιότητα της λευκής ουσίας του εγκεφάλου, γεγονός που μπορεί να υποδεικνύει πρώιμες ενδείξεις γήρανσης του εγκεφάλου.
Οι επιστήμονες διευκρινίζουν, ωστόσο, ότι η μελέτη δεν αποδεικνύει ότι το σύνδρομο πολυκυστικών ωοθηκών προκαλεί γνωστική έκπτωση, αλλά δείχνει μόνο μια συσχέτιση.
- Μυτιλήνη: Πυροσβεστικό αεροσκάφος «καρφώθηκε» με τη μύτη στο αεροδρόμιο
- Γιατί δεν αναρτήθηκαν αφίσες του Pride στο Μετρό; Η απάντηση - εξήγηση της ΣΤΑΣΥ
- Οι προβλέψεις Καμμένου για τις εκλογές: «Πολύ πάνω από 10% η Καρυστιανού, πιθανώς εκτός Βουλής το ΠΑΣΟΚ»
- «Eάν δεν είσαι εντάξει με το θέαμα, το πρόβλημα είναι δικό σου» - Η Τούνη απαντά για το μέγεθος του μαγιό της
Αυτό το άρθρο στο Reader δεν παρέχει ιατρικές συμβουλές και σε καμία περίπτωση δεν μπορεί να υποκαταστήσει τη γνωμάτευση ενός ιατρού. Για οποιοδήποτε πρόβλημα υγείας έχετε, θα πρέπει να απευθυνθείτε σε κάποιο επαγγελματία υγείας.